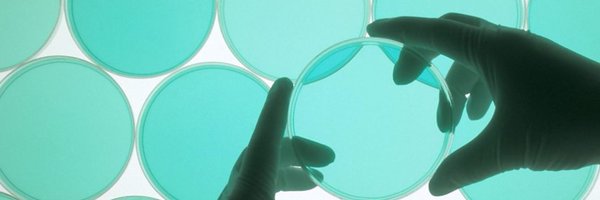
BBCScienceClub Profile Banner

BBC Science
@BBCScienceClub
Followers
36K
Following
194
Media
11K
Statuses
13K
The sound of BBC Science.
Joined October 2012
Bladder, bowels and sex: Learning to live after my mountain accident. Listen here on BBC Sounds: https://t.co/yIeBloeLmI
4
2
4
🧪 Do you have the energy and ideas to make compelling content at the leading-edge of science and health journalism? ⚕️ Help us establish a hub for science audio programmes across BBC Radio 4, the World Service and BBC Sounds 📻Apply here: https://t.co/TCCAJ3GlHF
2
1
3
🎶Living in a bacterial world 🎶 @smithamundasad investigates the microorganisms on us and around us for BBC Radio 4's Inside Health. 🎧More here: https://t.co/uMB7o37XHi
0
2
8
The BBC's Smitha Mundasad investigates the bacteria that live on her skin – and on her family’s dirty laundry. What’s there and why? 🎧Listen in full 📻 here:
bbc.co.uk
Exploring our microbial metropolis - and is being clean important for good health?
0
2
2
We're now able to detect potentially fatal illnesses years before they might cause harm. But do you really want to know what you might die from? 🎧Listen to The Screening Dilemma, a new BBC investigation📻
bbc.co.uk
Could good intentions to detect illnesses early actually be causing more harm?
0
0
2
The BBC CrowdScience team have been solving more listener questions over the past year. Now it's time to face one of their biggest challenges yet 🎶Can they SING a Xmas song? 🎤 https://t.co/laFRZTqO0T
0
0
1
It's not quite the new year yet, but we want you to send in YOUR new year's resolutions so we can put them in one of our shows! Just make a voice recording and email it over to crowdscience@bbc.co.uk.
0
1
2
How do cold and flu remedies actually work? Find out here in this new article - https://t.co/cA8aIq6B5Z Listen to the full episode of Inside Health here: https://t.co/MlYEc2cWTx
0
1
2
AI - could it be our digital friend? https://t.co/OdlxK5b5CE
bbc.co.uk
How will human potential change in the future?
2
6
29
🍗Is chicken on your menu? Globally, 74 billion of them are eaten every year and the industry is huge. Chris van Tulleken is on a quest - from coup to soup - to uncover the truth about the food we eat. Listen to Ep 1 in full now 🎧📻 https://t.co/jM8LoCxbOW
0
0
3
🍗How chicken got big🐔 Dr Chris van Tulleken unwraps the forces that shape what we eat. 🎧📻 https://t.co/T7uRpUSy86
0
2
12
🌨️ Wouldn't you like to skip winter -- and just hibernate like a bear? 🐻Scientists are working on it! Watch BBC Science producer Ella Hubber's video on the latest advances: https://t.co/ZFM8cSZNjM
1
1
1
🧮How do you rate your decision making? 📺 Watch BBC Science producer Julia Ravey's video: https://t.co/AwTXEAiumS
0
0
3
🐱How do cats purr ?? 😺 BBC Science producer Ella Hubber tells us how they do it: https://t.co/BJP4gfNv6c
0
0
2
🎼🌄When climate protesters in Switzerland interrupted this conductor's concert, his reaction surprised everyone – even the protesters. BBC Science in Action producer Ella Hubber explains 🎥 https://t.co/IsJjVoOBqN
0
1
8
Sit down 🪑. Stand up 🧍. Work ✍️. Repeat 🔁. How much sitting is too much? @JamesTGallagher heads into the lab to find out… BBC Radio 4 - Inside Health: https://t.co/mXBNU2C2Zh
@uniofleicester @LeicResearch @radio4 @BBCSounds
0
1
5
🌤️Is the 'sunshine cure' a real thing? ☀️The BBC's Marnie Chesterton investigates. Listen here: 🎧📻 https://t.co/9kqlZmdHLJ
0
0
3